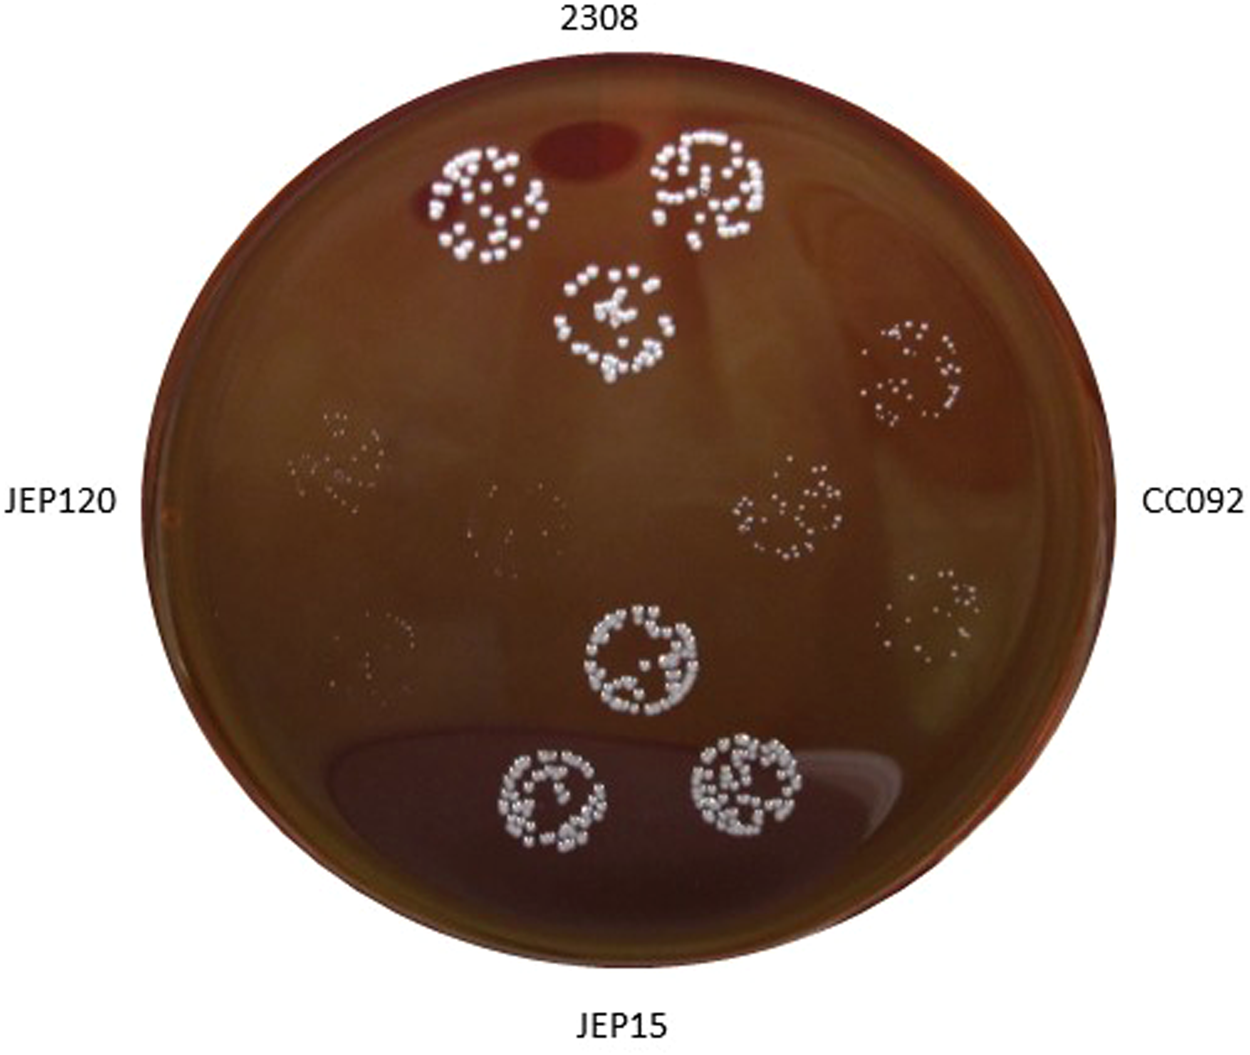
Figure 5

Figure 5
Colony formation by B. abortus 2308, an isogenic mucR mutant CC092 and derivatives of CC092 carrying plasmid-borne copies of mucR (JEP15) or mucRL36L39I40A (JEP120) following 72 h incubation at 37 °C on Schaedler agar supplemented with 5% defibrinated bovine blood.